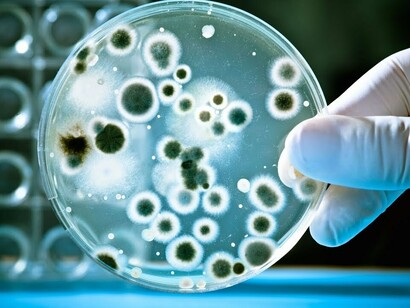
Microbi al microscopio

Le prime tracce di strutture biochimiche organizzate e capaci di replicarsi sono state rinvenute in alcune rocce sedimentarie della Groenlandia e risalgono a più di 3,7 miliardi di anni fa. In quel tempo l’ambiente terrestre era piuttosto inospitale: saturo di vapori velenosi come l’acido cianidrico e completamente privo di ossigeno. Per accogliere la vita delle piante e degli animali ci volle il tenace lavoro di microscopiche creature costituite da un’unica cellula: i cianobatteri e le alghe azzurre. Esse, in non meno di due miliardi di anni, utilizzando l’idrogeno presente in grandi quantità nell’acqua, liberarono nell’atmosfera un gas tossico per la maggior parte dei microorganismi, ma destinato a diventare l’elemento essenziale per la vita della terra: l’ossigeno.
Lungo il processo evolutivo che dalle prime proteine capaci di replicarsi ci ha accompagnato fino ai nostri giorni ci sono state due tappe che vale la pena di segnalare. La prima fu la nascita di un nuovo tipo di cellula dotata di nucleo e capace di produrre ossigeno attraverso piccoli organi (probabilmente il residuo di batteri) chiamati mitocondri. La seconda fu l’avvio del processo di aggregazione di questa cellula evoluta, chiamata eucariote, con altre cellule simili ma diversamente specializzate, in modo da formare organismi complessi, pluricellulari che nel corso di milioni di anni hanno dato origine all’immensa varietà delle specie viventi, di cui l’uomo è una delle ultime apparse sulla terra.
I microbi sono ovunque
I microbi sono dappertutto e in quantità straordinarie: basti pensare che da soli costituiscono più dell’80% di tutte le forme di vita messe insieme. La loro enorme diffusione potrebbe essere dovuta a due ragioni principali. In primo luogo alla loro incredibile velocità di riproduzione: in un solo giorno, una singola cellula ne può generare molti miliardi. Secondariamente, alla possibilità di vivere in condizioni estreme: nei vapori solfurei delle acque termali, tra le scorie radioattive dei reattori nucleari, negli abissi degli oceani e nelle viscere della terra. A ciò si aggiunga che i batteri sono dotati della singolare proprietà di scambiarsi direttamente le informazioni genetiche, favorendo così la rapida diffusione di nuove caratteristiche, come per esempio, la resistenza agli antibiotici. In pratica i microbi sono capaci di collaborare, scambiarsi informazioni e proteggersi dagli attacchi esterni come se il loro genoma (costituito da milioni di geni) appartenesse a un unico, immenso super-organismo 1.
La stragrande maggioranza dei microbi svolge funzioni essenziali per la vita: depurano l’acqua, decompongono le sostanze organiche, fertilizzano il suolo, captano l’azoto e l’ossigeno dall’aria, lievitano la farina e fermentano l’uva. La cooperazione con i microbi accompagna l’intero processo evolutivo e l’uomo, uno degli ultimi animali arrivati nell’albero della vita, ne ospita migliaia di miliardi, appartenenti a moltissime specie diverse e distribuiti un po’ ovunque. La loro presenza sulla cute, tra i capelli, nelle narici, in bocca, negli occhi, nell’intestino e perfino nei polmoni, ci aiuta a difenderci dalle aggressioni di agenti patogeni esterni di natura biologica, chimica e fisica. Complessivamente, il numero di batteri è di gran lunga maggiore delle cellule di cui siamo costituiti. In pratica, dal punto di vista dei microbi, siamo solo “un’incidente di percorso”, un mezzo per garantire la loro sopravvivenza.
In effetti, i batteri, da cui prende origine il 65% dei nostri geni 2, popolano il pianeta da miliardi di anni e potrebbero prosperare tranquillamente senza di noi; mentre un mondo senza microbi, diverrebbe in poco tempo un posto letale per gli animali, uomini compresi. Se qualcuno ha letto La guerra dei mondi di HG Wells, ricorderà che i marziani, la cui tremenda forza distruttrice ebbe il facile sopravvento sulla specie umana, furono annientati in pochi giorni proprio dai batteri, contro i quali i loro organismi si dimostrarono del tutto impreparati. Annientati, dopo che tutti i congegni umani erano falliti, dalle più umili creature che Dio nella sua saggezza ha posto su questa terra: i microbi.
Microbioma intestinale e salute
Il nostro sodalizio con i microbi inizia alla nascita, con la colonizzazione dell’intestino da parte dei batteri vaginali e fecali che il neonato riceve “in regalo” dalla mamma durante il parto. Una porzione consistente dei batteri che albergano nel nostro corpo si trova proprio nell’intestino, dove se ne contano almeno 100 trilioni, appartenenti a un migliaio di specie diverse. L’insieme dei genomi dei microbi, dei virus, dei funghi e dei protozoi che risiedono nell’intestino costituisce un complesso e delicato ecosistema a cui è stato dato il nome di microbioma. Se consideriamo che nel genoma umano sono stati individuati circa 23.000 geni e che in quello del microbioma se ne contano più di 3 milioni, possiamo renderci conto della sua importanza e delle sue eccezionali capacità di adattamento.
Negli ultimi anni, gli studi sulla composizione e sulle funzioni del microbioma si sono moltiplicati e hanno messo in evidenza i suoi effetti benefici nella digestione e nell’assorbimento degli alimenti, nella regolazione del sistema immunitario, nell’omeostasi del glucosio, nella modulazione dell’appetito e del peso corporeo e nel controllo dei meccanismi dell’infiammazione 3. Recentemente, inoltre, per il trattamento di severe infezioni intestinali da Clostridium difficile è stato proposto, con ottimi risultati, il trapianto del microbioma intestinale da donatori sani 4.
Una ridotta diversità delle specie batteriche che compongono il microbioma è stata riscontrata in un ampio spettro di patologie croniche, quali le malattie infiammatorie intestinali, l’obesità, l’artrite psoriasica, il diabete di tipo 1 e 2, la dermatite atopica e la depressione (2,3). Di conseguenza la diversità delle specie sembra un buon indicatore dello stato di salute, anche se sappiamo ancora poco sulla “giusta” composizione del microbioma.
L’ignoranza non è però un buon motivo per scoraggiare il mercato che ha già intravisto ottime opportunità di guadagno dall’analisi del microbioma di clienti reclutati con annunci promozionali di questo tipo: cattiva digestione, gonfiore addominale, alitosi, suscettibilità alle infezioni, nervosismo, ansia, disturbi del sonno, stanchezza, cambiamento dell’umore? Potrebbe essere una disbiosi intestinale. Ecco il test che devi fare: basta un piccolo campione di feci. Il fatto di sapere poco delle specie batteriche che dovrebbero essere rappresentate in un microbioma sano e di come potrebbero essere riequilibrate è del tutto irrilevante dato che qualunque sia il risultato, il trattamento è sempre lo stesso: adottare una dieta ricca di alimenti prebiotici (fibre) e assumere un probiotico, per poi ripetere il test dopo due o tre mesi. Per i probiotici il mercato offre un’ampia gamma di scelta. Si possono trovare prodotti specifici per i casi di cattiva digestione, per aumentare le difese immunitarie, per controllare il colesterolo, per il benessere delle vie urinarie, o semplicemente per soddisfare i propri gusti: fragola, mirtilli, ginseng o tropical. Insomma, il profumo dei soldi stimola come non mai la fantasia e dato che si può proporre qualsiasi cosa, non sono certo i creduloni a far difetto in questo mondo!
Prebiotici e probiotici: cosa sono e a che cosa servono
La composizione del microbioma è specifica per ogni persona e dipende dall’area geografica di residenza, dall’assunzione di farmaci come gli antibiotici e in particolare dal tipo di alimentazione. A questo riguardo la ricerca si è focalizzata soprattutto su due componenti: gli alimenti prebiotici e quelli probiotici.
Gli alimenti prebiotici contengono fibre non digeribili che sono fermentate dai microbi intestinali e favoriscono la crescita selettiva di una o di alcune specie batteriche che si presumono utili. Tali fibre sono presenti in molti prodotti vegetali come pomodori, aglio, cipolla, broccoli, cicoria, frutta secca, legumi, riso e farina di frumento integrali. Vi sono prove convincenti che diete ad alto contenuto di fibre siano associate alla riduzione della mortalità per malattie cardiovascolari, diabete e cancro del pancreas 5. Alcuni studi, inoltre, dimostrano che le diete prive di glutine, oggi di moda anche nelle persone non affette da celiachia, a causa del ridotto consumo di cereali integrali, diminuiscono il numero di specie batteriche benefiche e incrementano il rischio di malattie cardiovascolari 6.
I probiotici, invece, sono dei microorganismi vivi che somministrati in adeguate quantità possono conferire benefici effetti alla salute. Alimenti che contengono probiotici come lo yogurt e il kefir sono da secoli componenti abituali della dieta. Dato che i probiotici non sono farmaci per essere posti in commercio non richiedono alcuna preventiva dimostrazione di efficacia o di sicurezza, basta che sia garantita la presenza dei microorganismi dichiarati nell’etichetta. Ci sono solide prove scientifiche che la somministrazione di alcune specie di batteri è efficace per il trattamento della diarrea associata alla somministrazione di antibiotici, delle infezioni intestinali da Clostridium difficile, della colite ulcerativa e della stitichezza. Tuttavia per la maggior parte dei probiotici in commercio non vi sono chiare dimostrazioni di effetti benefici, soprattutto quando sono assunti da persone in buona salute 7.
Come abbiamo già detto, la mancanza di prove scientifiche non influenza le vendite dei probiotici che in dieci anni, grazie a messaggi promozionali che ne esaltano gli effetti salutari, sono più che raddoppiate. Non si parla mai invece dei possibili rischi associati all’uso dei probiotici, in particolare del fatto che senza adeguati controlli di sicurezza potrebbero essere poste in commercio specie batteriche resistenti agli antibiotici e in grado di trasferire la resistenza a germi patogeni 8.
Gli antibiotici: un’arma a doppio taglio
Abbiamo visto che la maggior parte dei microbi sono essenziali per la vita e che con loro abbiamo imparato a convivere, ricavandone reciproci benefici. Come ben sappiamo, però, non tutti i batteri ci sono amici! La storia dell’umanità è contrassegnata da spaventose epidemie. Peste, tubercolosi, lebbra, sifilide, colera, tifo hanno periodicamente flagellato l’umanità provocando milioni di morti, totalmente inermi di fronte a nemici di cui si ignorava perfino l’esistenza.
La scoperta degli antibiotici, negli anni Quaranta del secolo scorso, ha rappresentato uno dei più importanti eventi nella storia della medicina. I successi furono così strepitosi da illuderci che in breve tempo avremmo potuto vivere felici in un mondo finalmente liberato dalla terribile minaccia delle infezioni. Purtroppo le cose non sono andate proprio in questo modo, e oggi, pur avendo conseguito grandi successi, la battaglia contro i microbi è ben lungi dalla sua conclusione.
Data la loro grande efficacia e la scarsa consapevolezza delle possibili conseguenze negative, l’uso degli antibiotici si è andato progressivamente diffondendo anche per trattamenti del tutto inutili, come per esempio per la cura delle comuni infezioni respiratorie (raffreddore, rinosinusite, bronchite, sindromi influenzali), che nella maggior parte dei casi non sono di natura batterica e che si risolvono spontaneamente nel giro di una o due settimane. Un recente rapporto ha rilevato che circa un terzo della popolazione europea (43% in Italia) nel corso degli ultimi 12 mesi ha assunto antibiotici, nella maggior parte dei casi proprio per la cura di infezioni respiratorie 9. Inoltre, da quando gli allevatori americani hanno scoperto che i polli a cui venivano somministrate piccole dosi di antibiotici incrementavano il loro peso, questa pratica si è molto diffusa tra gli allevatori di polli, bovini e maiali, senza rendersi conto delle gravi conseguenze che essa poteva comportare per la salute umana.
Le conseguenze negative dovute all’utilizzo indiscriminato di antibiotici sono principalmente riconducibili a due fenomeni, entrambi in rapida crescita. Quello più conosciuto è la diffusione di batteri resistenti agli antibiotici. Basti pensare che in Europa, nel 2017 si sono registrate 4 milioni di infezioni dovute a batteri multiresistenti, responsabili di 37.000 morti: un po’ come se fosse iniziata la rivincita dei batteri descritta nella “Guerra dei mondi”!
L’altro fenomeno, non meno preoccupante, è invece dovuto all’azione deleteria degli antibiotici sulla composizione del microbioma intestinale. Vi sono, infatti, fondate prove che l’aumento di alcune patologie croniche, di cui abbiamo riferito sopra, siano almeno in parte attribuibili all’assunzione inconsapevole di antibiotici attraverso gli alimenti. L’aumento dell’obesità nei Paesi occidentali potrebbe essere una di tali conseguenze. In pratica, da bravi polli, ci stiamo trasformando in un immenso allevamento umano!
Conclusioni
Per lungo tempo abbiamo pensato che i microbi fossero dannosi o non servissero a nulla, ma appare sempre più chiaro che gli animali, uomini compresi, sono un delicato ecosistema che comprende il microbioma e più in generale i microbi dispersi nell’ambiente naturale. Non dobbiamo avere paura dei microbi ed essere ossessionati dall’igiene. I microbi sono ovunque e quelli presenti nel nostro corpo rappresentano un ecosistema che va rispettato. Per lavarci bastano acqua calda e sapone, l’uso di prodotti antibatterici, benché ampiamente pubblicizzati, non trova alcuna giustificazione e al contrario potrebbe danneggiarci.
Le ricerche sul microbioma sono solo all’inizio ma sono molto promettenti ed è ormai chiaro che il microbioma influisce in modo determinante sulla nostra salute e che un’alimentazione equilibrata e ricca di fibre contribuisce a farci star meglio. Gli antibiotici sono un’arma preziosa per il controllo dei germi patogeni. Usiamoli con saggezza. L’uso indiscriminato di antibiotici in ambito umano e nella zootecnia potrebbe avere conseguenze imprevedibili e molto gravi per nostra salute.
Bibliografia
1 Margulis L, Sagan D: Microcosmos. 1997.
2 Rook G et al: Evolution, human-microbe interactions, and life history plasticity. Lancet 2017; 390: 521-30.
3 Valdes AM et al: Role of the gut microbiota in nutrition and health. BMJ 2018; 361(Supp1): 36-44.
4 Spector T: Faecal trasplants. BMJ 2015;351:h5149.
5 Veronese N, Solmi M, Caruso MG, et al. Dietary fiber and health outcomes: an umbrella review of systematic reviews and meta-analyses. Am J Clin Nutr 2018; 107:436-44.
6 Lebwohl B, Cao Y, Zong G, et al. Longterm gluten consumption in adults without celiac disease and risk of coronary heart disease: prospective cohort study. BMJ 2017;357:j1892. doi:10.1136/bmj.j1892.
7 Kristensen NB, Bryrup T, Allin KH, et al. Alterations in fecal microbiota composition by
probiotic supplementation in healthy adults: a systematic review of randomized controlled trials. Genome Med 2016; published online 10 May. doi:10.1186/s13073-016-0300-5.
8 Cohen PA: Probiotic Safety—No Guarantees. JAMA Intern Med 2018; 178 (12): 1576-77.
9 Special Eurobarometer 445. Antimicrobial resistance. Report June 2016.